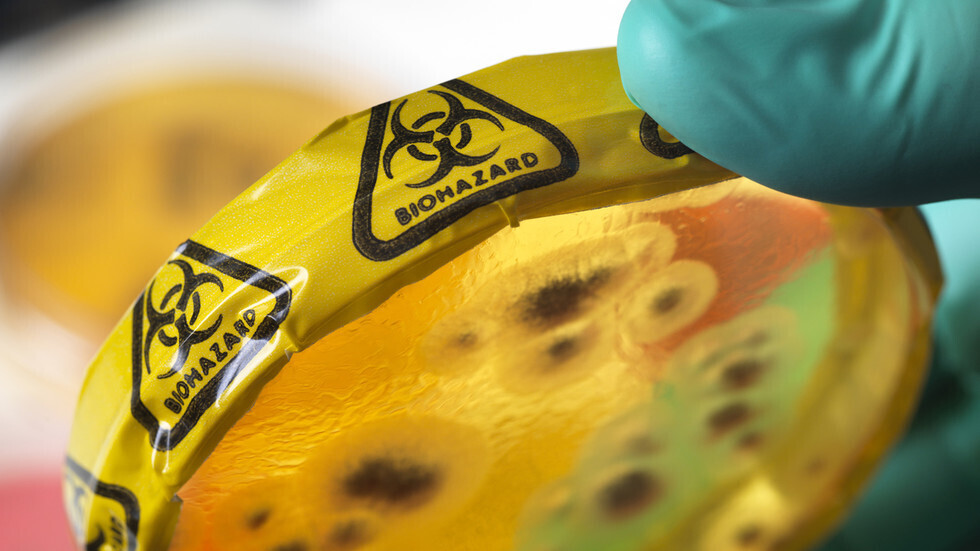
الطاعون الدبلي يودي بحياة شاب في منغوليا ويثير مخاوف من

Stories
-
كأس العرب 2025 في قطر
RT STORIES
قائمة أفضل هدافي كأس العرب 2025 قبل النهائي
#اسأل_أكثر #Question_MoreRT STORIES
في الملعب.. الأمير الحسين والأمير هاشم يحتفلان مع لاعبي الأردن بالتأهل لنهائي كأس العرب 2025 (فيديو)
#اسأل_أكثر #Question_MoreRT STORIES
منتخب الأردن يبلغ لأول مرة نهائي كأس العرب 2025 (فيديو)
#اسأل_أكثر #Question_MoreRT STORIES
المغرب أول المتأهلين إلى نهائي كأس العرب 2025 (فيديو)
#اسأل_أكثر #Question_MoreRT STORIES
شاهد.. هدف مغربي في مرمى الإمارات ضمن كأس العرب 2025
#اسأل_أكثر #Question_MoreRT STORIES
ما حدث في كأس العرب لا يليق بنا.. عصام الحضري يعتذر للجماهير المصرية (فيديو)
#اسأل_أكثر #Question_MoreRT STORIES
أرقام فلكية في كأس العرب.. كم سيحصل حامل اللقب؟!
#اسأل_أكثر #Question_MoreRT STORIES
نصف نهائي كأس العرب اليوم الاثنين.. صراع الحسم بين أربعة منتخبات عربية (الموعد + القنوات المفتوحة)
#اسأل_أكثر #Question_MoreRT STORIES
"بين الصداقة والتنافس".. مدرب الأردن يخوض موقعة السعودية محروما من الأسلحة الهجومية الرئيسية
#اسأل_أكثر #Question_MoreRT STORIES
الموعد والقنوات المفتوحة الناقلة لمباراة المغرب ضد الإمارات في نصف نهائي كأس العرب
#اسأل_أكثر #Question_MoreRT STORIES
مدرب منتخب السعودية قبل مواجهة الأردن: جمال السلامي يجب أن يتوقف الآن
#اسأل_أكثر #Question_More
كأس العرب 2025 في قطر
-
العملية العسكرية الروسية في أوكرانيا
RT STORIES
لافروف: الاتصالات مع الولايات المتحدة تبعث على الأمل
#اسأل_أكثر #Question_MoreRT STORIES
واشنطن بوست: منظومة الطاقة الأوكرانية عند حافة الانهيار
#اسأل_أكثر #Question_MoreRT STORIES
لأول مرة.. الاتحاد الأوروبي يفرض عقوبات على مواطن أمريكي بسبب دعمه لروسيا
#اسأل_أكثر #Question_MoreRT STORIES
الدفاع الروسية تعلن تحرير بلدة في دنيبروبيتروفسك
#اسأل_أكثر #Question_MoreRT STORIES
وزير الخارجية الهنغاري: لن ننجر للحرب التي تفتعلها أوروبا ضد روسيا!
#اسأل_أكثر #Question_MoreRT STORIES
لن نصمت إزاء هذه الجرائم الشنيعة.. موسكو تحيي ذكرى صحفيين قضوا على يد نظام كييف
#اسأل_أكثر #Question_MoreRT STORIES
روسيا.. الأمن الفيدرالي يوقف 10 مواطنين نفذوا أعمال تخريب بتوجيهات أوكرانية
#اسأل_أكثر #Question_MoreRT STORIES
مستشار سابق للبنتاغون: الاتحاد الأوروبي سيغير موقفه والنزاع الأوكراني سينتهي وفق سيناريو حرب فييتام
#اسأل_أكثر #Question_MoreRT STORIES
تدمير 201 مسيرة أوكرانية فوق أراضي روسيا منذ مساء الأحد
#اسأل_أكثر #Question_MoreRT STORIES
زيلينسكي يلمح إلى التخلي عن عضوية "الناتو" كحل وسط
#اسأل_أكثر #Question_MoreRT STORIES
الجيش الروسي يحرر بلدة أخرى في زابوروجيه
#اسأل_أكثر #Question_More
العملية العسكرية الروسية في أوكرانيا
-
خطة أمريكية للتسوية في أوكرانيا
RT STORIES
مسؤولون أمريكيون: تسوية نحو 90% من الخلافات بشأن اتفاق سلام في أوكرانيا
#اسأل_أكثر #Question_MoreRT STORIES
عميروف: المفاوضات مع الولايات المتحدة "بناءة ومثمرة" وتحرز تقدما
#اسأل_أكثر #Question_MoreRT STORIES
إعلام: اجتماع مستشاري ترامب وزيلينسكي في برلين كان "مثمرا”
#اسأل_أكثر #Question_MoreRT STORIES
الصحافة الفرنسية تكشف المطلب الأمريكي من أوكرانيا في مفاوضات السلام
#اسأل_أكثر #Question_MoreRT STORIES
"بوليتيكو": أوكرانيا رفضت مقترح واشنطن بإنشاء منطقة اقتصادية حرة في دونباس
#اسأل_أكثر #Question_MoreRT STORIES
بيسكوف: واشنطن لا تطلع موسكو مباشرة على مجريات مفاوضات برلين حول أوكرانيا
#اسأل_أكثر #Question_MoreRT STORIES
قادة أوروبيون يعتزمون الانضمام إلى محادثات أوكرانيا في ألمانيا
#اسأل_أكثر #Question_MoreRT STORIES
قائد كبير في الناتو يحضر محادثات برلين بين الولايات المتحدة وأوكرانيا
#اسأل_أكثر #Question_MoreRT STORIES
نائب رئيس الوزراء الإيطالي ينتقد قيادة الاتحاد الأوروبي بشأن روسيا ويدعو إلى الدبلوماسية
#اسأل_أكثر #Question_MoreRT STORIES
دبلوماسي بريطاني مخضرم يتحدث عن بند في خطة ترامب "سيدمر آمال زيلينسكي"
#اسأل_أكثر #Question_MoreRT STORIES
أوربان يشكك في بقاء روتّه بمنصبه بعد تصريحاته عن روسيا
#اسأل_أكثر #Question_MoreRT STORIES
أوشاكوف: لا نتوقع خيرا من مقترحات أوروبا وأوكرانيا وسنعترض بشدة على محاولات تمريرها
#اسأل_أكثر #Question_More
خطة أمريكية للتسوية في أوكرانيا
-
90 دقيقة
RT STORIES
بعد 24 ساعة.. لاعب ليفربول يخسر رقمه القياسي في البريميرليغ (فيديو)
#اسأل_أكثر #Question_MoreRT STORIES
في آخر منشور.. صلاح يحتفل برقم قياسي في الدوري الإنجليزي
#اسأل_أكثر #Question_MoreRT STORIES
سلوك مشين في الطائرة.. لاعب نادي الهلال كانسيلو يعتدي على راكب (فيديو)
#اسأل_أكثر #Question_MoreRT STORIES
متى ينوي رافيينا مغادرة برشلونة ؟
#اسأل_أكثر #Question_MoreRT STORIES
"فيفا'' يتغنى بمحمد صلاح قبل حفل "ذا بيست"
#اسأل_أكثر #Question_MoreRT STORIES
بينهم رونالدو.. 3 مستثمرين ينقضون على النصر السعودي
#اسأل_أكثر #Question_MoreRT STORIES
"فيفا" يكشف موعد إعلان أسماء الفائزين بجوائز الأفضل في العالم "The Best" والبث المباشر مجانا
#اسأل_أكثر #Question_MoreRT STORIES
موعد مرتقب لحسم مصير محمد صلاح مع ليفربول
#اسأل_أكثر #Question_MoreRT STORIES
مبابي يكشف سر احتفاله المثير أمام ألافيس (فيديو - صورة)
#اسأل_أكثر #Question_MoreRT STORIES
"ملكة الجليد الروسية" تدخل التاريخ بعرض على المحطة النووية العائمة الوحيدة في العالم
#اسأل_أكثر #Question_MoreRT STORIES
بعد الفوز على برايتون.. ليفربول يتلقى ضربة قوية
#اسأل_أكثر #Question_MoreRT STORIES
جدل واسع في برشلونة حول "جدارية لامين جمال" بعد تعرضها للتخريب
#اسأل_أكثر #Question_MoreRT STORIES
القنوات الناقلة والمجموعات العربية في أمم إفريقيا 2025 بالمغرب
#اسأل_أكثر #Question_MoreRT STORIES
"لا.. لسه.. دي مصر".. محمد صلاح يوجه رسالة قوية للفراعنة قبل أمم إفريقيا 2025 في المغرب
#اسأل_أكثر #Question_MoreRT STORIES
أزمة أرض نادي الزمالك تصل إلى النيابة العامة وتهديد لمجلس الإدارة بالإيقاف
#اسأل_أكثر #Question_MoreRT STORIES
لغة الجسد تفضح محمد صلاح
#اسأل_أكثر #Question_MoreRT STORIES
تأجيل عودة العلم والنشيد الروسيين إلى بطولات الشطرنج
#اسأل_أكثر #Question_MoreRT STORIES
ريال مدريد يفلت من كمين ألافيس ويواصل مطاردة برشلونة في صدارة "الليغا"
#اسأل_أكثر #Question_MoreRT STORIES
هل يودع صلاح ليفربول بعد كأس إفريقيا؟.. فان دايك يرد ويكشف موقفه
#اسأل_أكثر #Question_MoreRT STORIES
الإعلان الرسمي عن الصفقة خلال أيام.. كم سيدفع الوليد بن طلال للاستحواذ على الهلال السعودي؟
#اسأل_أكثر #Question_MoreRT STORIES
الاتحاد الدولي للشطرنج يعيد اللاعبين الروس إلى المنافسات الدولية مع رموزهم الوطنية
#اسأل_أكثر #Question_MoreRT STORIES
عرض سعودي ضخم للاستحواذ على نادي برشلونة المثقل بالديون
#اسأل_أكثر #Question_MoreRT STORIES
سلوت يكسر الصمت حول "وداع" صلاح.. مدرب ليفربول يعلق على إمكانية رحيل النجم المصري بعد كأس إفريقيا
#اسأل_أكثر #Question_MoreRT STORIES
رسميا.. دولة عربية تستضيف حفل منح جوائز "ذا بيست"
#اسأل_أكثر #Question_MoreRT STORIES
كم مباراة سيغيب محمد صلاح عن ليفربول خلال أمم إفريقيا؟
#اسأل_أكثر #Question_More
90 دقيقة
-
خطة ترامب لإنهاء الحرب في غزة
RT STORIES
"أكسيوس": البيت الأبيض وبّخ نتنياهو لانتهاكه وقف إطلاق النار في غزة بضربة جوية
#اسأل_أكثر #Question_MoreRT STORIES
خليل الحية: مهمة مجلس السلام رعاية وقف إطلاق النار وإعمار غزة
#اسأل_أكثر #Question_MoreRT STORIES
اغتيال ضابط أمني بمخيم المغازي وسط غزة.. وإسرائيل تنفي علاقتها
#اسأل_أكثر #Question_More
خطة ترامب لإنهاء الحرب في غزة
-
فيديوهات
RT STORIES
الشرطة الأمريكية تنشر فيديو جديدا لمنفذ الهجوم على جامعة براون بعد الفشل في تقفي أثره فورا
#اسأل_أكثر #Question_MoreRT STORIES
جنازة غير مسبوقة في نيجيريا.. رجل يدعى "النبي إرميا" يدفن والدته في تابوت ذهبي
#اسأل_أكثر #Question_MoreRT STORIES
لقطات جوية توثق لحظة تحييد مطلق النار على شاطئ بوندي بنيران الشرطة
#اسأل_أكثر #Question_MoreRT STORIES
أهالي غزة يشيّعون جثمان القيادي في حماس رائد سعد
#اسأل_أكثر #Question_MoreRT STORIES
والدا الشاب السوري الذي أنقذ عشرات اليهود من الموت في هجوم سيدني يعلقان على تصرفه
#اسأل_أكثر #Question_MoreRT STORIES
رئيس بيلاروس يقدم هدية تذكارية لدونالد ترامب وزوجته
#اسأل_أكثر #Question_MoreRT STORIES
لحظات ذعر بين طلاب جامعة أمريكية أثناء إطلاق نار مميت فيها
#اسأل_أكثر #Question_MoreRT STORIES
قناصة على سطح مبنى أثناء محادثات أمريكية أوكرانية في برلين
#اسأل_أكثر #Question_MoreRT STORIES
بعد ترميم دام عقدين.. الملك أمنحتب الثالث يعود إلى الأقصر
#اسأل_أكثر #Question_More
فيديوهات
-
من يصوت بدلا من القائد.. لماذا لا يدلي رونالدو بصوته في جوائز الفيفا؟
RT STORIES
من يصوت بدلا من القائد.. لماذا لا يدلي رونالدو بصوته في جوائز الفيفا؟
#اسأل_أكثر #Question_More -
بسبب مزاعم العنف المنزلي.. توبوريا لن يواجه الروسي إسلام ماخاتشيف حاليا
RT STORIES
بسبب مزاعم العنف المنزلي.. توبوريا لن يواجه الروسي إسلام ماخاتشيف حاليا
#اسأل_أكثر #Question_More
إصابة سنجاب بالطاعون الدبلي في أمريكا تشعل ضجة وردة فعل كبيرة عبر الإنترنت!
قال مسؤولو صحة محليون إن سنجابا من كولورادو الأمريكية ثبتت إصابته بالطاعون الدبلي بعد إجراء الاختبارات اللازمة، ما أثار جدلا في ظل ازدياد عدد الإصابات بـ"كوفيد-19" في البلاد.
وأُعلن عن اكتشاف القوارض المصابة من قبل هيئة الصحة العامة بمقاطعة جيفرسون (JCPH). وأشارت السلطة إلى أن السنجاب هو أول حالة إصابة بالطاعون في المقاطعة هذا العام.
وحذرت JCPH من أن "الطاعون هو مرض معد تسببه بكتيريا يرسينيا بيستيس (Yersinia pestis)، ويمكن أن يصاب به البشر والحيوانات المنزلية إذا لم تتخذ الاحتياطات المناسبة".
Bubonic Plague in Colorado??? The world wants us dead. I got my Zombie survival rules, do you?
— Beeshcake Barlos (@carlosssses) July 14, 2020
ويعد المرض الفظيع، الذي قضى على سكان العالم ثلاث مرات على الأقل خلال الأوبئة الضخمة على مدار التاريخ، نادرا للغاية في الوقت الحاضر. وما بين 1000 و2000 حالة من الطاعون ما تزال تُسجل في جميع أنحاء العالم كل عام، وتأتي بشكل رئيسي من جمهورية الكونغو الديمقراطية.
so a squirrel tested positive for bubonic plague in colorado today🙃 feels like we’re playing a real life game of jigsaw
— iree🤎 (@x_anoeri) July 14, 2020
Idk why everybody is freakin out about the bubonic plague. It def isn’t pleasant to have but yall know it’s treatable right ?? And it didn’t get eradicated so it still exists on earth so it’s not new for rodents to be carrying it still (albeit uncommon)
— akutagawa’s eyebrows (@cindaquil_) July 14, 2020
وفي الولايات المتحدة، تكون العدوى نادرة بشكل خاص، مع تسجيل زهاء 1000 حالة إصابة بالطاعون البشري منذ أكثر من قرن.
Like, how do they just find a random squirrel that has the bubonic plague? https://t.co/FvBCPfkM4K
— Sean Faska (@Sean7Faska) July 14, 2020
وفي حين أن احتمال تفشي الطاعون على نطاق واسع في الولايات المتحدة قريب من الصفر، إلا أن الأنباء عن إصابة السنجاب تسببت في ضجة كبيرة على مواقع التواصل الاجتماعي.
الطاعون الدبلي يودي بحياة شاب في منغوليا ويثير مخاوف من "جائحة أخرى"!
وقال الكثيرون، بشكل قاتم، إن أي شيء سيئ ممكن هذا العام، سواء كان تفشي وباء أو ظهور زومبي نهاية العالم أو نيزك قاتل.
وأشار العديد من المستخدمين إلى أن الطاعون الدبلي، الذي أحدث في السابق معدل وفيات مرعب يبلغ زهاء 95%، يمكن معالجته بشكل مثالي في الوقت الحاضر. على الرغم من أنه لا يوجد أحد في مأمن من الإصابة بأشكال أخرى من المرض - الالتهاب الرئوي القاتل وتسمم الدم المميت - إذا حدث تفش كبير فعليا.
واقترح بعض منكري مرض فيروس كورونا، أن قصة الطاعون هي ببساطة مسار جديد خططت له الحكومة مع تفشي جائحة "كوفيد-19". ويبدو أن أكثر من 3.3 مليون إصابة ونحو 140000 حالة وفاة في الولايات المتحدة وحدها، ليست مخيفة بما يكفي إحصائيا.
وفي الوقت نفسه، لم يأخذ البعض القصة على محمل الجد، وتمسكوا بالمزاح الخفيف حول الحظ السيئ للسنجاب، حيث يقترح أحدهم (ممازحا) أنه ينبغي على القوارض أن "ترتدي أقنعة" الآن، لمنع حدوث جائحة.
المصدر: RT
التعليقات